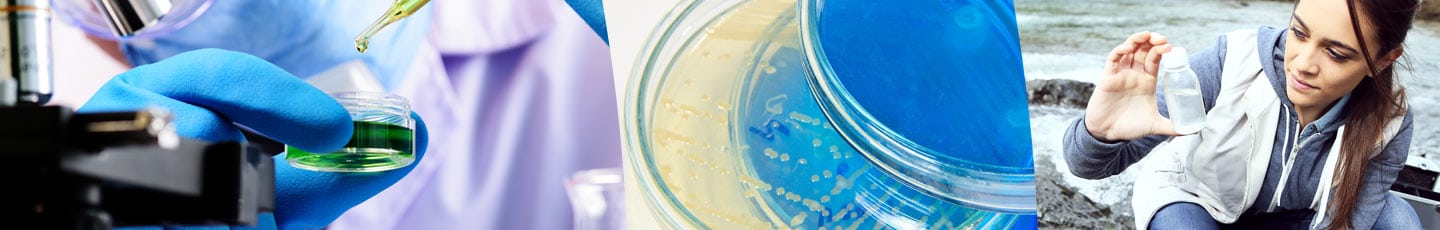
Licence Pro Analyse Chimique (LIPAC)

À Paris et dans la région Île-de-France, plusieurs écoles et universités proposent des formations en chimie, dans le cadre de l’alternance. Avec l’AFI 24, vous profiterez de multiples avantages : variété des diplômes proposés par des partenaires pédagogiques, inscription en ligne facilitée, services pour les futurs alternants. Cet article vous présente quelques-unes des licences en chimie à suivre via l’apprentissage.
Quelle licence de chimie sur Paris via l’apprentissage ?
Étudier à Paris, tout en travaillant comme alternant dans une entreprise francilienne vous permettra à la fois d’acquérir de solides connaissances théoriques et une première expérience professionnelle, dans un laboratoire de recherche ou dans le pharmaceutique ou un autre activité industrielle ayant besoin de chimiste.
Sur notre site, vous connaîtrez les différents diplômes Bac + 3. Vous pourrez ainsi suivre une licence Pro en chimie, spécialisée dans la formulation. Vous découvrez une présentation avec cette vidéo.
Ce diplôme peut former des alternants comme assistants ingénieurs, techniciens supérieurs en formulation et dans de multiples industries comme la cosmétique. Vous découvrez tous les débouchés professionnels et le programme de cette licence dont les cours se déroulent à Paris, dans le Cinquième arrondissement.
Si vous vous intéressez à l’analyse chimique, nous vous conseillons de consulter la fiche de formation concernant la licence Pro Analyse Chimique. Places disponibles, modalités pédagogiques et d’évaluation … vous connaîtrez tout au sujet de cette licence LIPAC.

Cependant, nous proposons aussi des formations d’établissements supérieurs situés dans divers départements franciliens. Ainsi, nous proposons de vous inscrire à la licence pro chimie formulation avec un parcours de formulation industrielle. Vous connaîtrez tout au sujet des objectifs de la formation. Nous affichons aussi tous les débouchés professionnels. Les cours ont lieu à Cergy Pontoise. Découvrez également le programme détaillé, avec la part de cours théoriques et le rythme de l’alternance.
Les avantages de l’AFI 24 pour les alternants chimistes en région parisienne
Nous avons présenté quelques-unes des formations organisées par des partenaires pédagogiques accueillant des alternants. Vous trouverez toutes les informations mais aussi la procédure à suivre pour être déclaré admissible. Vous pourrez ensuite suivre les cours dans une école ou une université, tout en étant présent dans une entreprise accueillant des alternants.
Par ailleurs, vous bénéficierez de l’accompagnement d’un référent pédagogique, à votre écoute pendant toute votre année de formation dans un établissement francilien.
Enfin, nous proposons parfois des contrats d’apprentissage dans des entreprises franciliennes ayant besoin d’alternants chimistes. Selon les disponibilités, des logements peuvent vous être proposés.
Découvrez aussi les opportunités de licences professionnelles en alternance, sur l’Île de France.
